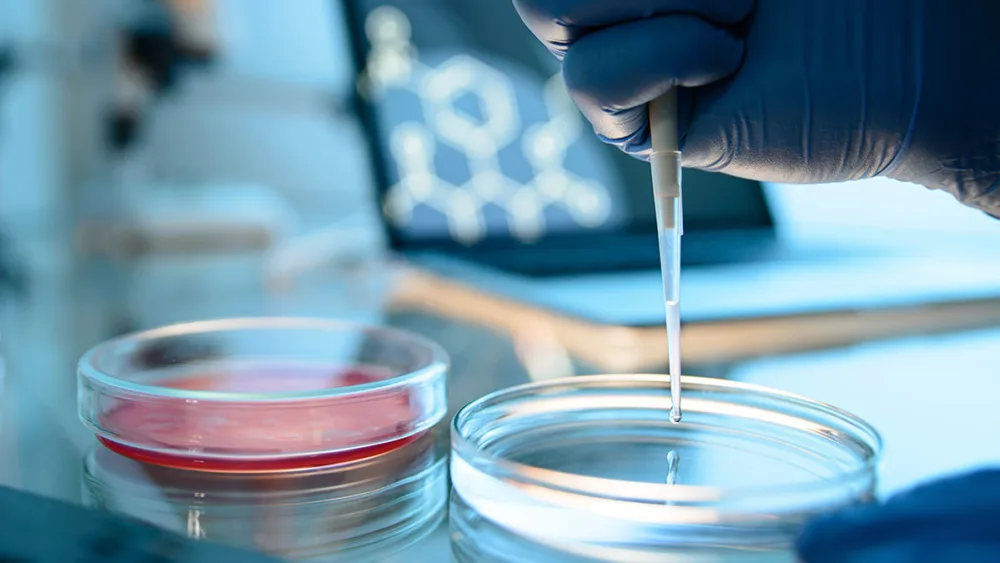
Μελέτη για την Έρευνα και την Καινοτομία στην Ελλάδα από τη διαΝΕΟσις​ και το DIW Berlin

Μελέτη για την Έρευνα και την Καινοτομία στην Ελλάδα από τη διαΝΕΟσις και το DIW Berlin
30/11/2016 | 13:36
07/08/2025 | 19:57
Πώς μπορεί η ελληνική οικονομία να επενδύσει στους υψηλής απόδοσης εξωστρεφείς κλάδους της τεχνολογίας και της καινοτομίας;
Πώς μπορεί η Ελλάδα να κρατήσει και να εκμεταλλευτεί αυτό το δυναμικό; Η διαΝΕΟσις δούλεψε με τους ερευνητές του Γερμανικού Ινστιτούτου Οικονομικών Ερευνών (DIW Berlin) για να περιγράψει τη σημερινή κατάσταση -και τις σημαντικές αδυναμίες- του ελληνικού συστήματος καινοτομίας, και να καταλήξει σε μια σειρά από απαραίτητες μεταρρυθμίσεις που θα επιτρέψουν στους κλάδους της τεχνολογίας και της καινοτομίας να αποτελέσουν μοχλό ανάπτυξης για την ελληνική οικονομία.
Τι είναι, όμως, η “καινοτομία”, σύμφωνα με τους ερευνητές; Ο όρος χρησιμοποιείται πολύ, κυρίως για να περιγράψει επιχειρηματικές προσπάθειες που σχετίζονται με τη “νέα οικονομία”, αλλά η ουσία του είναι ευρύτερη. Ουσιαστικά πρόκειται για τη διαδικασία μετατροπής μιας νέας ιδέας σε εμπορεύσιμο προϊόν ή υπηρεσία, σε μια νέα (ή βελτιωμένη) λειτουργική μέθοδο παραγωγής ή διανομής, ή σε μια νέα μέθοδο διοίκησης και οργάνωσης επιχειρηματικών πρακτικών. Δεν είναι το ίδιο πράγμα με την “εφεύρεση" ή την “ανακάλυψη” -είναι το επόμενο στάδιο. Η μεταμόρφωση αυτών σε εμπορεύσιμο προϊόν.
Το DIW Berlin, που διεξήγαγε την έρευνα για λογαριασμό της διαΝΕΟσις, έχει αναπτύξει ένα Δείκτη Καινοτομίας για την αξιολόγηση των ανά τον κόσμο συστημάτων καινοτομίας. Η τιμή του εξαρτάται από τις επιδόσεις του κάθε συστήματος (μιας χώρας, μιας πόλης, μιας περιοχής) σε μια σειρά από τομείς:
- Εκπαίδευση
- Έρευνα και Ανάπτυξη
- Δικτύωση
- Χρηματοδότηση
- Ρύθμιση
- Ποιότητα διακυβέρνησης & ζήτηση για καινοτομία
Όλες οι χώρες έχουν "σύστημα καινοτομίας" -ακόμα και η Ελλάδα-, αλλά, βεβαίως, δεν λειτουργούν όλα τους το ίδιο αποτελεσματικά. Πώς τα πάει, λοιπόν, το ελληνικό σύστημα καινοτομίας σ' αυτήν την αξιολόγηση;
Ανάμεσα σε 35 χώρες που αξιολόγησε το DIW Berlin, η Ελλάδα κατατάσσεται στην 29η θέση.
Πρόκειται για ένα βαθμό πάρα πολύ χαμηλό και μια θέση εξαιρετικά αρνητική, η οποία δεν έχει αλλάξει και πολύ τα τελευταία 15 χρόνια (στις έξι αξιολογήσεις που έγιναν από το 2000 μέχρι το 2015, η Ελλάδα κατατάσσεται πάντα μεταξύ 28ης και 30ης θέσης).
Η Ελλάδα είναι τελευταία ακόμα και στη ζήτηση για τεχνολογία και καινοτομία από το δημόσιο, και προτελευταία στην “ικανότητα προσέλευσης ταλέντων”
Και άλλες αξιολογήσεις της καινοτομίας στην Ελλάδα καταλήγουν σε παρόμοια συμπεράσματα. Ο “European Innovation Scoreboard”, που αξιολογεί την απόδοση των χωρών-μελών της Ε.Ε. καθώς και άλλων, κατατάσσει την Ελλάδα μαζί με χώρες όπως η Κροατία, η Ουγγαρία, η Πολωνία και η Πορτογαλία, κάτω από το μέσο όρο της Ε.Ε. Για το 2014, μάλιστα, οι επιδόσεις της χώρας έπεσαν στο 66% του ευρωπαϊκού μέσου όρου. Ο δε Παγκόσμιος Δείκτης Καινοτομίας, που εξετάζει 79 δείκτες σε 141 χώρες, τοποθετεί την Ελλάδα στην 45η θέση παγκοσμίως, και πάλι κάτω από το μέσο όρο της Ε.Ε.
Η ερευνητική ομάδα προχώρησε σε μια καταγραφή των χαρακτηριστικών στοιχείων του ελληνικού συστήματος καινοτομίας, συγκρίνοντάς το με τρεις κατηγορίες χωρών: Αυτές που έχουν παρόμοιο μέγεθος και παρουσιάζουν παρόμοιες επιδόσεις (Κροατία, Λετονία, Πολωνία, Πορτογαλία, Ουγγαρία), αυτές που πρωτοπορούν (Φινλανδία, Γερμανία, Σουηδία, Ολλανδία), και τη Ρωσία, που έκανε προσπάθειες βελτίωσης του συστήματος καινοτομίας της, οι οποίες εν πολλοίς απέτυχαν.
Στους επιμέρους δείκτες η Ελλάδα δεν έχει καλές επιδόσεις. Στην ικανότητα του εκπαιδευτικού συστήματος να ανταποκριθεί στις ανάγκες μιας ανταγωνιστικής οικονομίας, η Ελλάδα έρχεται τελευταία από όλες τις εξεταζόμενες χώρες. Η Ελλάδα επενδύει μόλις το 0,84% του ΑΕΠ της στην έρευνα (2014), ποσοστό γενικά χαμηλό, και σαφώς χαμηλότερο από των εξελιγμένων οικονομιών που επενδύουν ως και 3% των (κατά κανόνα πολύ μεγαλύτερων) ΑΕΠ τους. Η Ελλάδα μάλιστα είναι τελευταία από όλες τις εξεταζόμενες χώρες σε ιδιωτικές επενδύσεις στην έρευνα (μόλις 0,28% του ΑΕΠ), ενώ η έρευνα που διεξάγεται στα πανεπιστήμια και τα ερευνητικά ιδρύματα περιορίζεται κυρίως στη βασική και όχι στην εφαρμοσμένη έρευνα.
Παρ’ όλο που τα ελληνικά ερευνητικά ιδρύματα και τα πανεπιστήμια παράγουν ικανοποιητικό αριθμό επιστημονικών δημοσιεύσεων, ελάχιστες μετατρέπονται σε εμπορεύσιμα προϊόντα. Μόνο η Ρωσία και η Πολωνία έχουν λιγότερες αιτήσεις κατοχύρωσης ευρεσιτεχνίας ανά εκατομμύριο κατοίκους από την Ελλάδα.
Η πρόσβαση σε δάνεια και η διαθεσιμότητα επιχειρηματικών κεφαλαίων είναι επίσης πολύ περιορισμένη -η Ελλάδα είναι τελευταία στη λίστα και σ’ αυτόν τον τομέα, ενώ έρχεται στις τελευταίες θέσεις και σε όλους τους δείκτες που έχουν σχέση με τα θεσμικά προβλήματα (δείκτης Παγκόσμιας Τράπεζας για την ευκολία του επιχειρείν, δείκτης διαφθοράς, ποιότητα διακυβέρνησης).
Τα συμπεράσματα της αξιολόγησης μπορούν να συνοψιστούν στα εξής:
- Σε γενικές γραμμές, τα ελληνικά σχολεία, πανεπιστήμια και ερευνητικά ιδρύματα δεν είναι ανταγωνιστικά σε διεθνή κλίμακα.
- Οι δημόσιες και -ακόμη περισσότερο- οι ιδιωτικές επενδύσεις σε Ε&Α, είναι όλες πολύ χαμηλές.
- Τα δίκτυα ανάμεσα στη βασική έρευνα, την εφαρμοσμένη έρευνα και τις επιχειρήσεις χρειάζεται να επεκταθούν τόσο αριθμητικά όσο και ποιοτικά, προς τη κατεύθυνση της δημιουργίας περιφερειακών συνεργατικών σχηματισμών.
- Ο χρηματοπιστωτικός τομέας δεν παρέχει επαρκή επιχειρηματικά κεφάλαια για νεοφυείς εταιρείες και δάνεια για καθιερωμένες εταιρείες.
- Το ρυθμιστικό πλαίσιο, καθώς και το πολιτικό και κοινωνικό περιβάλλον δεν υποστηρίζουν και συχνά παρεμποδίζουν την καινοτομία και την επιχειρηματικότητα.
Παρά τις αδυναμίες αυτές, η Ελλάδα διαθέτει ορισμένα εφόδια που θα μπορούσαν, δυνητικά, να βοηθήσουν να αναβαθμιστεί η ποιότητα του συστήματος καινοτομίας της:
- Έναν μικρό αριθμό κορυφαίων ερευνητικών ιδρυμάτων.
- Έναν μικρό αριθμό επιχειρήσεων μέσης και υψηλής τεχνολογίας, π.χ. στον τομέα της πληροφορικής και στον φαρμακευτικό τομέα, καθώς και μερικές αξιόλογες νεοφυείς επιχειρήσεις στον τομέα της πληροφορικής στην Αθήνα.
- Μια αξιόλογη διασπορά στην έρευνα, στα χρηματοοικονομικά και στις επιχειρήσεις.
- Ελκυστικό κλίμα και υψηλό βιοτικό επίπεδο, που συνιστούν μοναδικό συγκριτικό πλεονέκτημα έναντι των περισσοτέρων κρατών-μελών της ΕΕ.
Πώς όμως μπορούν αυτά τα προτερήματα να μεταμορφωθούν σε ριζική αναβάθμιση της ποιότητας του ελληνικού συστήματος καινοτομίας; Η έρευνα καταλήγει σε μια σειρά από προτάσεις.
Ένα βιώσιμο και αποτελεσματικό σύστημα καινοτομίας απαιτεί τη χάραξη μακροπρόθεσμης στρατηγικής, κάτι που στο ρευστό ελληνικό πολιτικό τοπίο δεν είναι εύκολα εφικτό. Η έρευνα περιγράφει μια σειρά από απαραίτητες παρεμβάσεις που πρέπει να γίνουν σε συγκεκριμένους τομείς, ώστε η Ελλάδα να αναβαθμίσει το εγχώριο σύστημα καινοτομίας της και να αρχίσει να απολαμβάνει τα οφέλη. Ενδεικτικά:
1. Νομοθετικό και κανονιστικό περιεχόμενο
Οι απαραίτητες μεταρρυθμίσεις περιλαμβάνουν τη μείωση της γραφειοκρατίας, την άρση των διοικητικών βαρών για το άνοιγμα, τη λειτουργία και το κλείσιμο των επιχειρήσεων, την εισαγωγή της ηλεκτρονικής διακυβέρνησης, την απλοποίηση της νομοθεσίας, την απλοποίηση και σταθεροποίηση της φορολογικής πολιτικής. Πρόκειται για σημαντικές παρεμβάσεις -πολλές από τις οποίες ήδη έχει αναλύσει σε άλλες της έρευνες η διαΝΕΟσις- οι οποίες αφορούν ολόκληρη τη λειτουργία της οικονομίας της χώρας -αλλά είναι και εντελώς απαραίτητες για τη λειτουργία ενός συστήματος καινοτομίας. Η παρούσα έρευνα περιέχει μια σειρά από τέτοιες παρεμβάσεις, από τη θέσπιση ενός συμβουλίου ρυθμιστικού ελέγχου μέχρι την εφαρμογή των περισσοτέρων από τις 300 συστάσεις του ΟΟΣΑ για την άρση των εμποδίων στην επιχειρηματικότητα, και από τις αλλαγές στον πτωχευτικό κώδικαώς την επιτάχυνση της λειτουργίας της δικαιοσύνης.
2. Έρευνα και Ανάπτυξη
Οι δαπάνες για Ε&Α στην Ελλάδα είναι εξαιρετικά χαμηλές. Οποιαδήποτε Εθνική Στρατηγική για την καινοτομία θα πρέπει οπωσδήποτε να περιλαμβάνει σχεδιασμό για τη ραγδαία αύξησή της. Η πρότασή μας είναι μια σταδιακή, αλλά πολύ σημαντική αύξηση που θα φτάσει τα επόμενα χρόνια μέχρι και το 3% του ΑΕΠ. Παράλληλα, η έρευνα μεταξύ άλλων προτείνει τη δημιουργία νέων ιδρυμάτων και ερευνητικών φορέων που θα διεξάγουν εφαρμοσμένη έρευνα για να πλαισιώσουν τα μεγάλα ιδρύματα βασικής έρευνας της χώρας (Δημόκριτος, ΙΤΕ, ΕΚΕΤΑ, ΕΠΙΣΕΥ, Επιστημονικό Πάρκο Πάτρας) με χρηματοδότηση, μεταξύ άλλων, από το Πρόγραμμα Horizon 2020 "teaming for excellence" -ένα πρόγραμμα για το οποίο η ελληνική κυβέρνηση δεν έχει καν υποβάλλει αίτηση.
Τα νέα ιδρύματα, καθώς και οι νέες κοιτίδες καινοτομίας, τα πανεπιστήμια και τα υφιστάμενα ιδρύματα θα πρέπει να αναπτύξουν συνεργατικούς σχηματισμούς, οργανωμένους κατά τα διεθνή πρότυπα, με αυστηρή αξιολόγηση, ανεξάρτητη διοίκηση, εξασφαλισμένη ανεξαρτησία και κίνητρα για την προσέλκυση των υψηλού επιπέδου Ελλήνων ερευνητών, πολλοί από τους οποίους τα τελευταία χρόνια μεταναστεύουν.
3. Εκπαίδευση
Το επίπεδο του ελληνικού εκπαιδευτικού συστήματος κρίνεται κατά κανόνα ως χαμηλό, σε σύγκριση με τα ευρωπαϊκά δεδομένα, τουλάχιστον. Η ραγδαία βελτίωση των ψηφιακών δεξιοτήτων του πληθυσμού, η ριζική αναβάθμιση της ανώτερης εκπαίδευσης με ενίσχυση των πρωτοπόρων, καινοτόμων τμημάτων των πανεπιστημιακών ιδρυμάτων, η έμφαση στις STEM σπουδές και η εισαγωγή της επιχειρηματικότητας ως αναπόσπαστου μέρους του εκπαιδευτικού συστήματος είναι απαραίτητες κινήσεις, που βεβαίως περιγράφουν μια εξ ολοκλήρου καινούρια και καινοτόμα προσέγγιση στο θέμα της τριτοβάθμιας εκπαίδευσης, πολύ διαφορετική από την υπάρχουσα.
4. Χρηματοδότηση
Το βασικό πρόβλημα της χρηματοδότησης των καινοτόμων επιχειρήσεων επηρεάζεται ασφαλώς τόσο από την τρέχουσα οικονομική συγκυρία στη χώρα, όσο και από το προβληματικό κανονιστικό της πλαίσιο, που αποθαρρύνει τις ξένες επενδύσεις αλλά και γενικότερα την επιχειρηματικότητα στη χώρα. Η έρευνα προτείνει μια σειρά από κινήσεις, όπως η εισαγωγή φορολογικών κινήτρων για δαπάνες Ε&Α από ιδιωτικές επιχειρήσεις, ένα πρόγραμμα επιδοτήσεων για καινοτόμες επιχειρήσεις (στα πρότυπα του γερμανικού EXIST), την ωρίμανση της αγοράς των ελληνικών venture capital και την καλύτερη αξιοποίηση (και μόχλευση) των ευρωπαϊκών επενδυτικών κονδυλίων.
5. Δικτύωση
Η έρευνα επισημαίνει το φαινόμενο της γεωγραφικής διασποράς των σημαντικών ελληνικών ερευνητικών ιδρυμάτων ανά την επικράτεια και εισηγείται τη μεταγκατάστασή τους (παρά το υψηλό κόστος), τη δημιουργία συμπράξεων -και των απαραίτητων δομών διαχείρισης των συμπράξεων-, και τη διευκόλυνση της ώσμωσης ανάμεσα στα ερευνητικά κέντρα, τα πανεπιστήμια και τις επιχειρήσεις.
6. Κοινωνία
Όλα τα παραπάνω προϋποθέτουν πολύ σοβαρές και βαθιές τομές στην ελληνική πολιτική πραγματικότητα, μεταρρυθμίσεις πολύ μεγαλύτερης κλίμακας από αυτές που έχουμε δει από το πολιτικό μας σύστημα μέσα στα τελευταία χρόνια των μνημονίων. Πρόκειται για μια σειρά απο δύσκολες πολιτικές αποφάσεις, οι οποίες προϋποθέτουν μια ξεκάθαρη στρατηγική στόχευση στο θέμα της έρευνας και της καινοτομίας. Κι ένα τέτοιο όραμα δεν μπορεί να προκύψει χωρίς να αποτελέσει πρώτα αίτημα της κοινωνίας. Η έρευνα αναγνωρίζει πως για να μπορέσει μια ελληνική κυβέρνηση να προτείνει και να υλοποιήσει μια τέτοια πολιτική, θα πρέπει πρώτα να δημιουργήσει το κατάλληλο πολιτικό και κοινωνικό περιβάλλον που θα είναι έτοιμο να τη δεχτεί. Αυτό το περιβάλλον, μεταξύ άλλων, θα πρέπει να εμπλουτιστεί με Έλληνες ερευνητές και επιχειρηματίες που έχουν εγκαταλείψει τη χώρα. Αυτό το εξαιρετικά υψηλής ποιότητας ανθρώπινο δυναμικό χρειάζεται κίνητρα για να επιστρέψει. Επιπλέον, χρειάζεται μια αλλαγή υποδείγματος στο ελληνικό επιχειρείν, η οποία συνδέεται με την άρση ενός σημαντικού κοινωνικού φραγμού που έχει να κάνει με το φόβο της αποτυχίας.
Αλλά κυρίως χρειάζεται η βούληση για μια στροφή του παραγωγικού μοντέλου της ελληνικής οικονομίας από τον αποτυχημένο εσωστρεφή χαρακτήρα που είχε μέχρι το ξέσπασμα της κρίσης, στον εξωστρεφή, καινοτόμο και ανταγωνιστικό χαρακτήρα που περιγράφεται και στη σχετική έρευνα της διαΝΕΟσις για τον "Χάρτη Εξόδου" από την κρίση.
Διαβάστε ολόκληρη την έρευνα στα ελληνικά και τα αγγλικά, εδώ.

Σχολιάστε